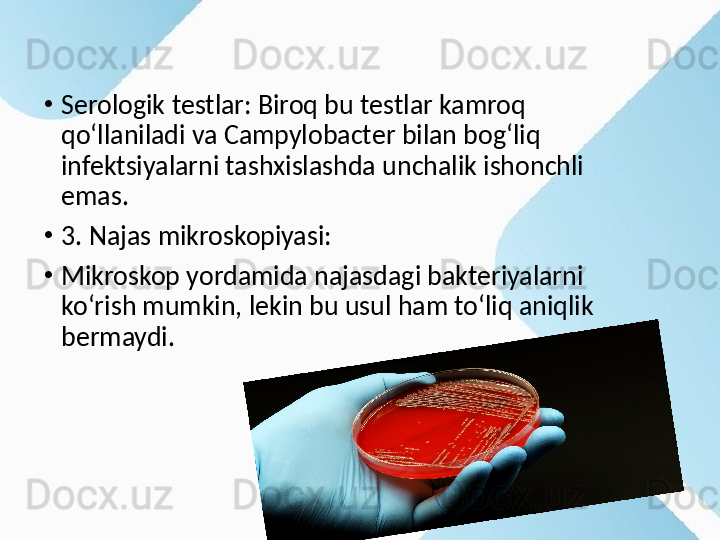

Дата регистрации 11 Апрель 2025
3 ПродажKampliobakterioz. Etiologiyasi, patogenezi, epidemiologiya, klinikasi, diagnostika

Kampliobakterioz. Etiologiyasi, patogenezi, epidemiologiya, klinikasi, diagnostika